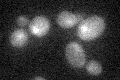
YLR247C
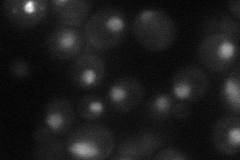
YLR247C
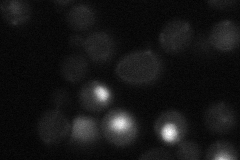
YLR247C
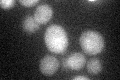
YLR247C
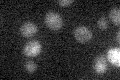
YLR247C

View description
Putative helicase; localizes to the mitochondrion and the nucleus; YLR247C is not an essential gene; null mutant displays increased levels of spontaneous Rad52p foci
Localization:
Intensity:
Fold change:
Significance:
-
C’ GFP library in SD
nucleus17.66 -
N' NOP1pr-GFP in SD
nucleus38.3479 -
N' TEF2pr-mCherry in SD

nucleus21.5632 -
N' NATIVEpr-GFP in SD
nucleus21.5557 -
N' TEF2pr-VC and Cyto-VN in SD

below threshold26.3065 -
C’ GFP library in SD+DTT
nucleus15.680.88No -
C’ GFP library in SD+H2O2

nucleus18.111.02No -
C’ GFP library in Starvation Media
nucleus16.040.9No -
C’ GFP library on the background of Pup2-DaMP

nucleus -
C’ GFP library on the background of CCT mutant

nucleus19.34131.0948No
